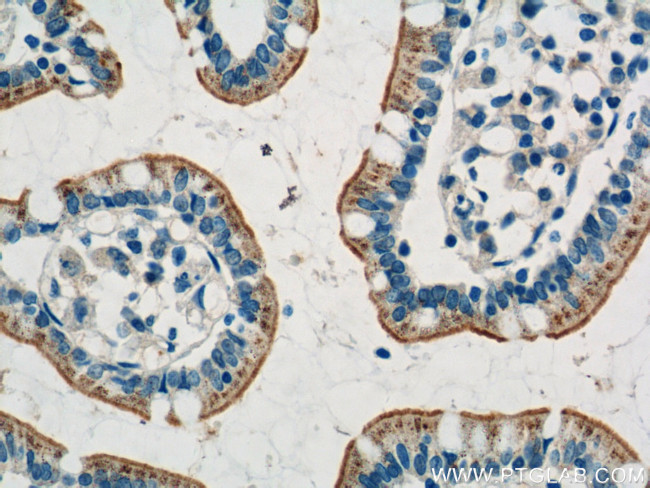
HTR3A Antibody in Immunohistochemistry (Paraffin) (IHC (P))

Search
Proteintech
HTR3A Polyclonal Antibody
{{$productOrderCtrl.translations['antibody.pdp.commerceCard.promotion.promotions']}}
{{$productOrderCtrl.translations['antibody.pdp.commerceCard.promotion.viewpromo']}}
{{$productOrderCtrl.translations['antibody.pdp.commerceCard.promotion.promocode']}}: {{promo.promoCode}} {{promo.promoTitle}} {{promo.promoDescription}}. {{$productOrderCtrl.translations['antibody.pdp.commerceCard.promotion.learnmore']}}
产品信息
10443-1-AP
已发表种属
宿主/亚型
分类
类型
抗原
偶联物
形式
浓度
规格
保存条件
运输条件
产品详细信息
Immunogen sequence: MLLWVQQAL LALLLPTLLA QGEARRSRNT TRPALLRLSD YLLTNYRKGV RPVRDWRKPT TVSIDVIVYA ILNVDEKNQV LTTYIWYRQY WTDEFLQWNP EDFDNITKLS IPTDSIWVPD ILINEFVDVG KSPNIPYVYI RHQGEVQNYK PLQVVTACSL DIYNFPFDVQ NCSLTFTSWL HTIQDINISL WRLPEKVKSD RSVFMNQGE (1-208 aa encoded by BC002354 )
靶标信息
The product of this gene belongs to the ligand-gated ion channel receptor superfamily. This gene encodes subunit A of the type 3 receptor for 5-hydroxytryptamine, a biogenic hormone that functions as a neurotransmitter, a hormone, and a mitogen. This receptor causes fast, depolarizing responses in neurons after activation. It appears that the heteromeric combination of A and B subunits is necessary to provide the full functional features of this receptor, since either subunit alone results in receptors with very low conductance and response amplitude. Alternatively spliced transcript variants encoding different isoforms have been identified.
仅用于科研。不用于诊断过程。未经明确授权不得转售。